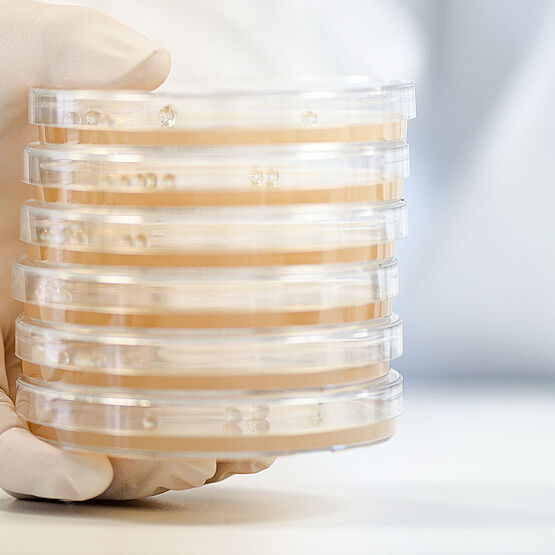
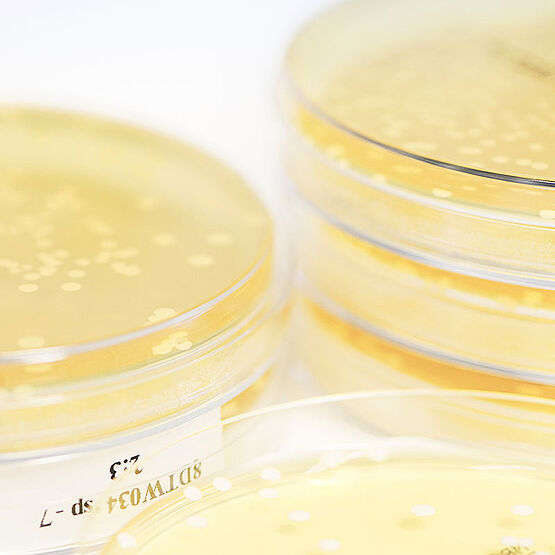

Izvirne ideje za praznična darila
December je tukaj – čudovit, a pogosto tudi nekoliko stresen čas prazničnih priprav. Se tudi vi pogosto sprašujete, kaj podariti svojim bližnjim in otrokom? Hkrati pa si ne želite, da bi otroci prejeli preveč igrač, temveč bi jih raje spodbudili k cenjenju pravih vrednot? Popolnoma vas razumemo – zato vam ponujamo nekaj navdihujočih idej.